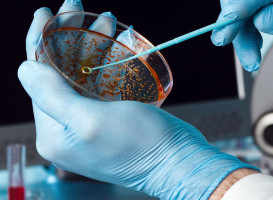

Česká asociace výrobců a dodavatelů diagnostik in vitro CZEDMA
Asociace výrobců a dodavatelů diagnostik
- IČ: 70916811
- DIČ: CZ70916811
|
Adresa provozovny
Sídlo společnosti |
Na Ořechovce 475/58, 16200 Praha
Rybná 716/24, 11000 Praha |
|
Telefon
|
+420 602 139 221 |
|
Telefon
|
+420 602 139 221 |
|
E-mail
|
[email protected] |
|
Web
|
www.czedma.cz |
Fotografie této firmy
* Informace o této společnosti pochází z veřejně dostupných zdrojů a rejstříků a nemusí být zcela přesné.